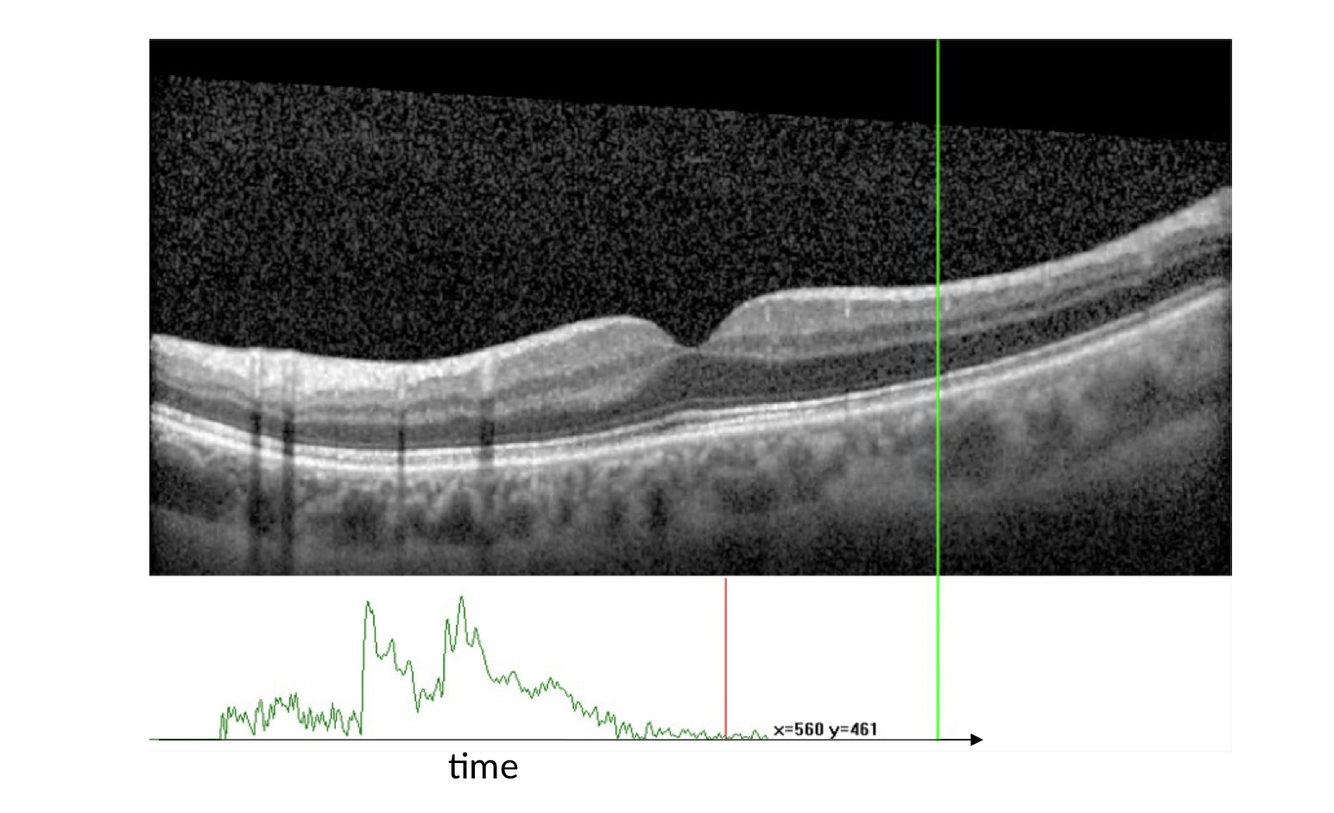

What does OCT stand for?
Optical Coherence Tomography
What does tomography mean?
Produces images by sections
This is a nice way of what an OCT shows, just for your information

Does an OCT only image the retina?
No- it can image other parts of the eye such as the cornea too
What are the 2D scans called from an OCT?
B-scans
What are B-scans made up from
A group of A-scans
What are c-scans?
A bunch of b-scans to see a structure in 3D, useful in investigating structures in the Renita
How does a Time domain OCT work?
- infrared light is split into two arms by a beam splitter
- these arms are sample arm and reference arm
- There is a mirror that reflects the light back
- The amount of light reflected back is dependent on reflectivity values of different tissues

What does the green line show?
An A scan
How are successive A-scans taken?
The mirror is tilted
What do Frequency-domain OCTs involve?
No mirror movement, Uses a broadband interference of using different frequencies of the light source which corresponds to different penetration in the tissues instead
Name two technologies of OCTs that use frequency-domain OCT?
Spectrum domain OCT (SD-OCT)
Swept source OCT (SS-OCT)
What is a pro of frequency-domain OCTs?
Faster
What is a broadband light source ?
A beam containing multiple frequencies
How does SD-OCT work?
Just like how we described FD-OCTs
The light goes through a dispersive detector and processes wavelengths individually which reconstructs the A-scan

How do SS-OCTs work?
Uses different wavelengths in the light sources and reconstructs an a-scan by decoding these signals over time

How do SS-OCTs work?
Uses different wavelengths in the light sources and reconstructs an a-scan by decoding these signals over time

What are 12 layers of the retina seen on an OCT?
1) Internal limiting membrane
2) Retinal nerve fibre layer
3) Ganglion cell layer
4) Inner plexiform layer
5) Outer plexiform layer
6) Outer nuclear layer
7) External limiting membrane
8) Photoreceptor layer
9) Retinal pigment epithelium
10) Bruch’s membrane
11) Choriocapillaries
12) Choroidal stroma

In terms of glaucoma, what can an OCT detect ?
Thinning of the NFL
What is OCT angiography used for?
Use to investigate the health of the retinal vasculature
What is another name for a c-scan?
A volume
What are the four applications of an OCT in glaucoma?
- Optic nerve assessment
- Posterior pole assessment
- OCT angiography
- Anterior segment OCT
What is the type of scan that is used to assess optic nerve damage?
Circular scan
Which layer are we concerned about of the retina in glaucoma ?
NFL















